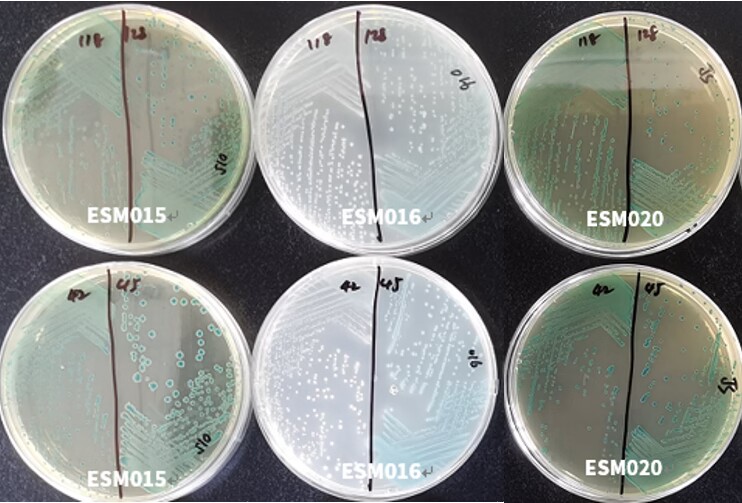
GB 4789.40-2024克羅諾桿菌檢驗標(biāo)準(zhǔn)變更解讀 GB 4789.40-2024克羅諾桿菌檢驗標(biāo)準(zhǔn)變更解讀

克羅諾桿菌的簡介
克羅諾桿菌(Cronobacter)是一種革蘭氏陰性的無芽孢短小桿菌,屬于腸桿菌科,是一種兼性厭氧的條件性致病菌。在顯微鏡下呈球桿狀或成對排列,有時也可呈短鏈狀,大小為(0.6μm-1.1μm)×(1.2μm-3.0μm),周身鞭毛,有動力,廣泛分布于嬰幼兒配方粉、奶粉、奶酪、水果、蔬菜、肉制品以及自然環(huán)境中。
? ? ? ?克羅諾桿菌曾被認(rèn)為是產(chǎn)黃色素的陰溝腸桿菌,1980年法默等通過不同菌株之間的DNA雜交、生化、血清等特性,將其正式更名為阪崎腸桿菌,2008年又重新將其定義為克羅諾桿菌屬。該菌屬共包括7個種和3個亞種,即阪崎克羅諾桿菌、蘇黎世克羅諾桿菌、都柏林克羅諾桿菌(含有3個亞種:都柏林克羅諾桿菌都柏林亞種、都柏林克羅諾桿菌洛桑亞種、都柏林克羅諾桿菌乳粉亞種)、穆汀斯克克羅諾桿菌、丙二酸鹽陽性克羅諾桿菌、康迪蒙提克羅諾桿菌和尤尼沃斯克羅諾桿菌。模式種為阪崎克羅諾桿菌,模式菌株為ATCC 29544。
克羅諾桿菌的檢驗標(biāo)準(zhǔn)的更新
? ? ? ?在2024年2月8日頒布的GB 4789.40-2024版本中,在適用范圍中增加了嬰幼兒輔助食品,即新標(biāo)準(zhǔn)適用于嬰幼兒配方食品、?嬰幼兒輔助食品、 乳及乳制品及其原料中克羅諾桿菌的檢驗。

(圖片來源于GB4789.40-2024)
克羅諾桿菌定性檢驗
1.?前增菌和增菌
? ? ? ?取檢樣100 g(mL) 置無菌容器中, 加入900 mL 已預(yù)熱至41℃±1℃?的緩沖蛋白胨水用手緩緩地?fù)u動至充分溶解,36 ℃ ±1 ℃ 培養(yǎng)18 h±2 h。移取1 mL 轉(zhuǎn)種于10 mL mLST-Vm 肉湯,41.5℃±1℃培養(yǎng)24 h±2 h。
? ? ? ?由于取樣量較大,如用到剪刀勺子等工具,需提前高壓滅菌,也可以使用無菌的大均質(zhì)袋來進(jìn)行前增菌,便于節(jié)省空間。培養(yǎng)時,需防止均質(zhì)袋翻倒造成液體溢灑及封口不當(dāng)發(fā)生污染。
BPW預(yù)熱至41℃±1℃有助于粉狀樣品充分溶解,也避免了因液體較多升溫較慢引起的增菌失敗。必要時,可拍打均質(zhì)袋使粉狀樣品充分溶解混勻,BPW相較于無菌生理鹽水等能更好地使受損或缺乏營養(yǎng)的細(xì)菌恢復(fù)生長。

BPW
? ? ? ? 克羅諾桿菌屬具有較強(qiáng)的耐滲透壓能力和較好的耐熱性,且對萬古霉素天然耐藥,因此使用的改良月桂基硫酸鹽胰蛋白胨(mLST-Vm)肉湯在提供了良好營養(yǎng)的條件下利用高濃度的氯化鈉和萬古霉素,且在41.5℃±1℃培養(yǎng),能有效的抑制革蘭氏陽性菌和其他不耐滲透壓、不耐熱的細(xì)菌生長。之前2016版標(biāo)準(zhǔn)中44℃的選擇性增菌溫度,是因為該溫度與ISO 22964-2006相同,但目前國際普遍認(rèn)為該溫度可能抑制部分受損傷的克羅諾桿菌生長,容易導(dǎo)致污染樣品發(fā)生漏檢。?因此ISO 22964-2017已將選擇性增菌溫度由44 ℃±0.5 ℃修改為41.5 ℃±1 ℃,2024版的新標(biāo)準(zhǔn)也進(jìn)行了相應(yīng)的調(diào)整。

mLST-Vm

(圖片來源于GB4789.28-2024)
2. 分離
輕輕混勻?mLST-Vm 肉湯培養(yǎng)物, 各取增菌培養(yǎng)物1 環(huán), 分別劃線接種于兩個阪崎腸桿菌顯色培養(yǎng)基平板, 36 ℃ ±1 ℃ 培養(yǎng)24 h±2 h, 或按商品化培養(yǎng)基的要求條件進(jìn)行培養(yǎng)。
顯色培養(yǎng)基
目前北京陸橋有三款適用于克羅諾桿菌檢驗的顯色培養(yǎng)基。由于標(biāo)準(zhǔn)未規(guī)定產(chǎn)品配方,客戶可根據(jù)需求任選其一。
ESM015 克羅諾桿菌顯色培養(yǎng)基(DFI):樣品干擾菌少時可選擇。
ESM016 克羅諾桿菌顯色培養(yǎng)基:對樣品中的干擾菌有更好的選擇性和分辨性。
ESM020 克羅諾桿菌顯色培養(yǎng)基(CCI):ISO22964-2017標(biāo)準(zhǔn)中CCI瓊脂。


ATCC 29544阪崎克羅諾桿菌在三種培養(yǎng)基上的生長情況
樣品分離干擾菌在三種培養(yǎng)基上的生長情況

? ? ? ? ? ? ? ? ? ? ? ? ? ? ? ?注:CCI在實際表現(xiàn)中與DFI相近
每個平板挑取至少5 個可疑菌落, 不足5個時挑取全部可疑菌落, 劃線接種于 TSA 平板。36?℃ ±1 ℃培養(yǎng)24?h±2?h。
有文獻(xiàn)報道和相關(guān)檢測中發(fā)現(xiàn),部分克羅諾桿菌不產(chǎn)黃色素,因此在新標(biāo)準(zhǔn)中,刪除了黃色素的生化鑒定項目。
3.鑒定
自TSA平板上直接挑取可疑菌落, 進(jìn)行生化鑒定。克羅諾桿菌屬的主要生化特征見標(biāo)準(zhǔn)中的表3。可選擇生化鑒定試劑盒或全自動微生物生化鑒定系統(tǒng)。新標(biāo)準(zhǔn)中,刪除了苦杏仁苷生化項目。

(圖片來源于GB4789.40-2024)
4. 分子生物學(xué)檢測
隨著乳制品生產(chǎn)企業(yè)和相關(guān)監(jiān)管部門對檢測方法時效性和準(zhǔn)確性需求的日益迫切,傳統(tǒng)的檢測方法雖然準(zhǔn)確可靠,但操作繁瑣、工作量大、耗時較長,已不能滿足快檢的要求。而分子生物學(xué)的檢測方法,由于其具有特異性強(qiáng)、準(zhǔn)確性高且快速的優(yōu)勢,近年來被逐漸引入到食品微生物的檢測標(biāo)準(zhǔn)(例如GB 4789.6-2016)中。SN/T 1632.3-2013出口奶粉中阪崎腸桿菌(克羅諾桿菌屬)檢驗方法中就有關(guān)于克羅諾桿菌熒光PCR的檢測方法。在新的克羅諾桿菌檢測標(biāo)準(zhǔn)中也增加了PCR鑒定的方法,將其作為選做內(nèi)容。
? ? ? 北京陸橋的MX-1301克羅諾桿菌屬核酸檢測試劑盒,采用熒光PCR的檢測技術(shù),對克羅諾桿菌屬的特異性基因進(jìn)行檢測,且含有內(nèi)標(biāo)基因,只根據(jù)其擴(kuò)增曲線即可進(jìn)行判定,簡便快捷,可根據(jù)需求進(jìn)行菌液或菌落的鑒定,極大的豐富了克羅諾桿菌的鑒定手段。


克羅諾桿菌屬核酸檢測試劑盒及阪崎克羅諾桿菌熒光PCR結(jié)果圖
5.結(jié)果與報告
綜合菌落形態(tài)、生化鑒定或PCR鑒定結(jié)果, 報告每100 g(mL) 樣品中檢出或未檢出克羅諾桿菌屬。
點擊查看:GB 4789.40-2024克羅諾桿菌檢測產(chǎn)品列表